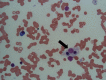

Disseminated tuberculosis presenting with secondary haemophagocytic lymphohistiocytosis and Poncet's disease in an immunocompetent individual
- PMID: 23563676
- PMCID: PMC3644889
- DOI: 10.1136/bcr-2012-008265
Disseminated tuberculosis presenting with secondary haemophagocytic lymphohistiocytosis and Poncet's disease in an immunocompetent individual
Abstract
We report a 27-year-old previously healthy man, who presented with fever and painful swelling of both ankles for 6 months, and who had been jaundiced for 1 week. Clinical examination revealed diffuse macular rash, severe pallor, deep icterus, generalised lymphadenopathy and hepatosplenomegaly. Detailed evaluation revealed granulomata in bone marrow aspirate, and numerous acid fast bacilli in lymph node biopsy. Bone marrow PCR was also positive for Mycobacterium tuberculosis. A diagnosis of disseminated tuberculosis was made and antitubercular therapy was initiated. Investigation also showed features of haemophagocytosis within the bone marrow. Results of further tests satisfied the criteria for haemophagocytic lymphohistiocytosis, probably secondary to tuberculosis. However, rapid deterioration in his clinical condition led to his death within 5 days of diagnosis, before appropriate therapy for haemophagocytic lymphohistiocytosis could be instituted. This case report highlights an unusual and deadly presentation of tuberculosis in an immunocompetent individual.
Figures

References
-
- Scott R, Robb-Smith AH. Histiocytic medullary reticulosis. Lancet 1939;2013:194–8
-
- Yarali N, Yildrim I, Arik E, et al. Hemophagocytic syndrome associated with bacterial infections. J Pediatr Inf 2010;2013:162–4
-
- Henter JI, Horne A, Arico M, et al. HLH-2004: diagnostic and therapeutic guidelines for hemophagocytic lymphohistiocytosis. Pediatr Blood Cancer 2007;2013:124–31 - PubMed
Publication types
MeSH terms
LinkOut - more resources
Full Text Sources
Other Literature Sources
Medical